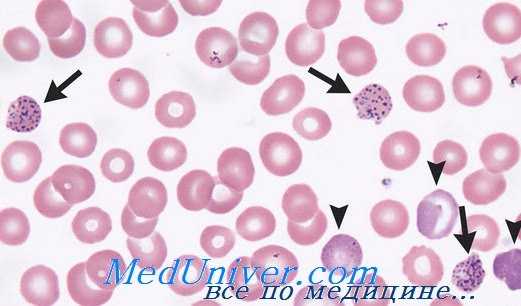

Вторичная сидеробластическая анемия - анемии, вызываемые изониазидотерапией и отравлением свинцом
Добавил пользователь Алексей Ф. Обновлено: 11.12.2025
Наследственная сидеробластическая анемия - анемия, реагирующая на пиридоксин
Наследственная сидеробластическая анемия описана Gooley и Rundles. Первые выявленные случаи четко указывали на отношение к мужскому полу, в связи с чем их назвали и «связанных с полом», причем передача этой анемии рецессивная.
Преимущественное поражение мужчин подсказывает мысль о том, что нарушение наследственного характера, составляя рецессивную черту, связанную с хромосомой X.
У женщин-носителей выявлены гипохромные эритроциты. В этих аномальных эритроцитах обнаруживалось также наличие связанного с хромосомой X антигена — Хга, в то время как нормальные эритроциты не содержали такого антигена. Результаты наблюдения рассматривались как способ передачи, связанный с хромосомой X (Cartwright, Lee).
Такого рода анемии развиваются у подростков, им характерны признаки сидеробластической анемии с выраженной эритроцитной гипохромией, а весьма часто — и гемохроматозом.
Гейльмейер, назвавший это заболевание «наследственной сидеробластической анемией», исследовал также метаболизм гема данных больных, обнаружив недостаток копропорфириноксидазы. По этой причине количество протопорфирина в эритроцитах меньше, в то время как копропорфирина — в избытке.

Отдельными авторами был отмечен и недостаток дельтааминолевулинсинтетазы. Эти биохимические аномалии были обнаружены и у членов соответствующих семей.
Гейльмейер описал также вид наследственной болезни, не связанной с полом (II тип), в которой нарушение происходит на первой фазе синтезирования протопорфирина, именно при переходе а-амино-b-кетоадипиновой кислоты в дельта-аминолевулиновую кислоту. В моче обнаружен эстер (гидразон) а-амино-b-кетоадипиновой кислоты.
Лечение заключается в назначении крупных доз (250 мг/сутки) пиридоксина, фолиевой кислоты, комплексонов железа (десферал), а в случае надобности и переливания крови.
Анемия, реагирующая на пиридоксин
Анемия, реагирующая на пиридоксин - этим названием обозначена крупная группа анемий, которые, морфологически, похожи на наследственные анемии (эритроцитная гипохромия, кольчатые сидеробласты, гемохроматоз и пр.), «поддающиеся лечению крупными дозами пиридоксина». Этот вид анемии не развивается за счет недостатка пиридоксина, уровень которого в крови нормальный, но видимо он не преобразуется в активную форму — пиридоксалфосфат (Beaupre и Growney).
Чрезмерная нагрузка триптофаном обусловливает появление в моче промежуточных продуктов его катаболизма (за отсутствием активного пиридоксина), таких как кинуренин и ксантуреновая кислота. Внимательный анализ ряда случаев этой анемии выявил бесспорно семейный характер заболевания (Medal и сотр.).
В настоящее время проявляется тенденция включения этой болезни в крупную группу наследственных сидеробластических анемий, которые, как было доказано, в размере 50% дают положительный ответ на лечение пиридоксином крупными дозами (т.е. примерно 250—300 мг/сутки, в то время как 5 мг/сутки пиридоксина в принципе назначаются для приведения к норме недостатка пиридоксина, например при отравлении ГИНК и пр.).
Редактор: Искандер Милевски. Дата обновления публикации: 18.3.2021
Вторичная сидеробластическая анемия - анемии, вызываемые изониазидотерапией и отравлением свинцом
Вторичная сидеробластическая анемия. Наблюдения многих лет привели к заключению, что сидеробластическая анемия развивается при различных заболеваниях (ревматоидном артрите, синдроме неполноценного поглощения, карциноме, алкоголизме, лечении изониазидом, сатурнизме и пр.).
Характеристика вторичной сидеробластической анемии одинакова с описанной выше. Однако, в противоположность первичным формам, при которых клеймо болезни — кольчатые сидеробласты — остается даже после положительного терапевтического воздействия, вторичная анемия отличается восстановлением нормальных функций костного мозга по удалении причины.
Наиболее частыми формами вторичной сидеробластической анемии считаются обусловленные изониазидотерапией и отравлением свинцом.
Анемия, вызываемая изониазидотерапией
Анемия, вызываемая изониазидотерапией (ГИНК) (Бутояну, McCurdy, Wintrobe) обычно проявляется на 4—6 месяце лечения; развивается также после лечения циклосерином или пиразинамидом.
Для устранения анемии следует прекратить лечение данным медикаментом или назначить больному пиридоксин.
Сидеробластическая анемия от отравления свинцом
Анемия, вызываемая отравлением свинцом
Морфологическая характеристика анемии вызванной отравленим свинцом соответствует гипохромной анемии с кольчатыми сидеробластами и неполноценным кроветворением. Дополнительно отмечается и характеристика гемолитической анемии (превышающий норму ретикулоцитоз, повышенный показатель косвенного билирубина в крови и пр.) в связи с сокращением продолжительности жизни эритроцитов (Буторяну, Wintrobe).
Другая весьма важная характеристика, представляющая диагностическую ценность, заключается в базофильно-пунктированном аспекте значительного числа эритроцитов (чаще, чем при других видах сидеробластической анемии).
Диагноз анемии, обусловленной отравлением свинцом основывается на клиническую и выше описанную морфологическую картины (рези в животе, свинцовая кайма на деснах), на определение свинца в моче (нормальный показатель составляет 90 мкг/сутки), равно как и на выделение с мочой увеличенного количества дельта-аминолевулиновой кислоты (норма 3 мг/л) и копропорфирина (норма 50 мкг/сутки) (Haeger-Aronsen).
Видимо патогенез эти изменений довольно сложный. Предполагается, что свинец поражает эритробласты, оболочку эритроцитов и синтез протопорфирина.
Терапия заключается в удалении больного из загрязненной свинцом среды и назначении этилендиамина четырехуксуснокислого, как фактор, комплексирующий свинец, и тем самым способствующий его выделению (0,5—1 г/сутки).
Однако более важной представляется профилактика этого заболевания, заключающаяся в целесообразных мероприятиях охраны труда и периодическом контроле подвергающихся влиянию свинца рабочих. Периодический контроль состоит из исследования мазка периферической крови и определения показателя свинца в моче.
Сидеробластические анемии - причины, классификация
Сидеробластические анемии составляют особую группу заболеваний весьма разнообразной этиологии, которых, однако, объединяет общий знаменатель — наличие кольчатых сидеробластов в костном мозге (Bjorkman, Bowman). Последние рассматриваются патологическими и отличаются от нормальных — зерна феритина которых распространены по всей цитоплазме — тем, что железо располагается в гребешках митохондриев в виде железистых мицелиев (пластинок или пыли).
К другим общим характеристикам этих анемий можно отнести неэффективность эритропоэза, рост показателя железа в плазме и тканях и развитие гемохроматоза (Farid, Мунтяну и Попеску).
В медицинской литературе уже давно говорилось об этой болезни, включенной в крупную группу так называемых устойчивых анемий, поскольку они не поддавались никакому терапевтическому методу. Но постепенно, по мере освоения новых клинических и разведочно-лабораторных достижений, определилось, что некоторые из этих заболеваний отличаются четкой этиологией (отравление свинцом, длительное лечение изониазидом, ревматоидный артрит и пр.).
Другие — благоприятно реагируют на пиридоксинотерапию крупными дозами (сохраняя вместе е тем нормальный уровень пиридоксина в крови), в связи с чем получили название «анемий, реагирующих на пиридоксин». И наконец, наблюдение отдельных семейных случаев (Gooley, Bundles и Falls) сделало возможным отождествление наследственных форм болезни.
Однако имеется большая группа подобных заболеваний, с хорошо установленными клиническими и морфологическими характеристиками, получившая название первичной генуинной сидеробластической анемии, в отношение которой этиология еще не определена. Современная классификация этой болезни приведена ниже. Связанное с морфологическим пороком наличия кольчатых сидеробластов, это название было присвоено недавно (Bjorkman). Гейльмайер, основательно и многосторонне исследовавший эту болезнь, назвал ее сидероаккрестической анемией (вызываемой неиспользованием железа).

Классификация сидеробластических анемий
A. Первичные формы сидеробластических анемий:
I. Первичная приобретенная генуииная сидеробластическая анемия
II. Наследственная сидеробластическая анемия:
а) вид, связанный с полом, развивающийся за счет недостатка аминолевулин-синтстазы и копропорфириногеноксидазы (I тип по Гейльмейеру);
б) аутосомальный вид (поражающий лиц обоего пола) (II тип по Гейльмейеру),
Б. Анемия, поддающаяся пиридоксинотерапии
B. Вторичные формы сидеробластических анемий
I. Вызываемые токсическими веществами или медикаментами, в том числе, свинцом, гидразидом изоникотиновой кислоты, циклосерином, спиртом и пр.
II. Сопутствующие иным заболеваниям, в том числе, воспалительным (ревматизм, коллагеноз, заражение почек), крови (миелофиброз, истинная полицитемия, лейкемия, гемолитическая анемия, злокачественная анемия и пр.), прочим болезням (поздняя порфирия кожи, резецированный желудок, миксэдема и др.).
Общая гематологическая характеристика сидеробластических анемий:
1) Гипохромия или/и эритроцитный диморфизм.
2) Ретикулоцитопения.
3) Эритробластоз — костномозговой мегалобластоз.
4) Кольцевые сидеробласты.
5) Неполноценное кроветворение: внутрикостномозговое расплавление крови при высоких показателях косвенной гипербилирубинемии и уробилиногена в фекалиях, гиперсидеремия, клиренс и интенсивность и скорость метаболизма, высокий показатель Fe59, слабое-включение Fe59 в эритроциты, депонирование железа в запасах.
6) Нормальная продолжительность жизни эритроцитов.
7) Отсутствуют аномальные гемоглобины.
Сидеробластная анемия ( Сидероахрестическая анемия )
Сидеробластная анемия – это приобретенное или наследственное заболевание крови, характеризующееся гипохромией эритроцитов, высоким уровнем сывороточного железа с отложением в тканях органов. Клиническая картина представлена анемическим синдромом (головокружение, утомляемость, бледность кожи), гемосидерозом внутренних органов (гепатомегалия, кардиомегалия, ХПН), изменением картины крови. Диагноз выставляется на основании клинических и биохимических анализов (ОАК, сывороточное Fe, ферритин, трансферрин, витамин В6), генодиагностики, исследования миелограммы. Лечение может включать гемотрансфузии, витамино-, гормонотерапию, хелаторную терапию.
МКБ-10
Общие сведения
Сидеробластные (сидероахрестические) анемии включают несколько гетерогенных синдромов, которые протекают с нарушением синтеза гема, несмотря на повышенное содержание железа в плазме. Популяционная частота сидеробластных анемий (СБА) не выяснена ввиду их клинической неоднородности, однако известно, что приобретенные формы встречаются чаще наследственных. Врожденные анемии обычно манифестируют в детстве, но могут оставаться нераспознанными вплоть до зрелого возраста. Первичная приобретенная сидеробластная анемия диагностируется преимущественно у лиц среднего и пожилого возраста.
Причины
Врожденная сидеробластная анемия
Врожденные СБА связаны с мутациями в генетическом материале. Они различаются по типу наследования и патогенетическому механизму:
- Х-сцепленные сидеробластные анемии. Один вариант обусловлен дефектами гена ALAS2 ‒ синтазы дельта-аминолевуленовой кислоты II типа (локус Хр11.21). Другой тип болезни связан с трансгенациями hABC7 (Xp13.1-q13.3), кодирующего белок, участвующий в транспорте гема.
- Аутосомно-рецессивная сидеробластная анемия. Генетически гетерогенная группа. Может возникать при дефекте гена WFS1 (4p16.1), отвечающего за экспрессию трансмембранного белка вольфрамина. В этом случае СБА диагностируется в рамках синдрома Вольфрама (DIDMOAD). Другая форма развивается при дефектах в гене SLC25A38, кодирующем белок-транспортер глицина, необходимый для синтеза гема.
- Митохондриальная цитопатия. Вызвана делециями митохондриальной ДНК, клинически проявляется развитием синдрома Пирсона.
- Спорадические сидеробластные анемии. Обусловлены появлением вновь возникших генетических мутаций, которые отсутствуют у родителей и других членов семьи.
Приобретенная сидеробластная анемия
Идиопатические (первичные) СБА ‒ рефрактерные анемии с кольцевыми сидеробластами ‒ рассматриваются как разновидность миелодиспластического синдрома (МДС) и занимают в его структуре 5-15%. Чаще возникают как следствие лучевой или цитостатической терапии, проводимой по поводу коллагенозов, гемобластозов, различных онкопроцессов. Риск развития МДС повышен у курильщиков, лиц, контактирующих с химическими веществами (бензином, растворителями, инсектицидами).
Вторичная сидеробластная анемия может быть этиологически связана со следующими факторами:
- прием антибактериальных и туберкулостатических препаратов (хлорамфеникол, линезолид, изониазид, циклосерин);
- интоксикация свинцом;
- хронический алкоголизм;
- нарушение баланса витаминов и микроэлементов: дефицит пиридоксина (витамина В6), недостаток меди, избыток цинка;
- коллагенозы;
- болезни крови (полицитемия, гемолитическая анемия).
Патогенез
Независимо от многообразия причин все они тем или иным путем приводят к нарушению образования гема. Гем является соединением, состоящим из протопорфирина и атома железа (Fe2+). При его связывании с белком глобином образуется гемсодержащий хромопротеин гемоглобин, главная функция которого заключается в транспорте кислорода к тканям, а углекислоты из тканей.
При СБА в результате дефектов ферментных систем, дефицита пиридоксальфосфата, токсического влияния или других факторов нарушается биосинтез протопорфирина, что делает образование гема невозможным, несмотря на достаточный уровень Fe в сыворотке крови. Развивается гипохромная анемия. В условиях, когда железо не используется клетками, оно начинает накапливаться в тканях и внутренних органах с развитием их дисфункции.
Классификация
Сидеробластные анемии делятся на 2 большие группы – наследственные и приобретенные, внутри которых выделяют конкретные клинические формы, связанные с определенными этиофакторами:
1. Наследственные сидеробластные анемии:
- Х-сцепленные;
- аутосомные (могут быть пиридоксин-рефрактерными и пиридоксин-зависимыми);
- митохондриальные болезни.
2. Приобретенные сидеробластные анемии:
- первичные ‒ клональные СБА в рамках миелодиспластического синдрома;
- вторичные ‒ обратимые СБА (лекарственные, токсические, алиментарные);
- на фоне других заболеваний (системных, гематологических и пр.)
Симптомы сидеробластной анемии
В клинической картине сидероахрестических анемий преобладают две группы симптомов: циркуляторно-гипоксические и недостаточность органов, обусловленная гемосидерозом. Гематологические изменения выявляются при диагностическом исследовании крови и костного мозга.
Гипоксический синдром сопровождается недомоганием и слабостью, тахикардией, снижением АД. Характерны жалобы на головокружение, ноющие боли в сердце, появление «мушек» перед глазами, одышку при движениях. Отмечается сухость и бледность кожи, ломкость ногтей. У детей ухудшается запоминание учебного материала, снижается успеваемость.
Депонирование железа приводит к развитию гепатоспленомегалии, а в поздних стадиях – циррозу печени. Поражение поджелудочной железы сопровождается манифестацией сахарного диабета. Гемосидероз миокарда проявляется кардиомегалией, нарушением ритма, сердечной недостаточностью. Отложение железа в тканях мужских половых желез вызывает вторичный гипогонадизм. При поражении легких возникает дыхательная недостаточность, почек – ХПН.
Осложнения
Перегрузка железом вызывает необратимые органные поражения, приводящие к стойкой функциональной недостаточности сердца, печени, почек, эндокринных органов. Таким пациентам требуется пожизненная заместительная и поддерживающая терапия, у них снижена общая продолжительность жизни. Течение идиопатической формы сидеробластной анемии у 5-10% пациентов осложняется острым лейкозом, рефрактерным к полихимиотерапии.
Диагностика
Основанием для выставления диагноза «сидеробластная анемия» служат клинические и лабораторные данные. Больных консультирует врач-гематолог, при необходимости – генетик, токсиколог, ревматолог, нарколог. Опорными диагностическими критериями выступают:
- Гемограмма. Характерные изменения периферической крови включают снижение Hb и ЦП, возможна ретикулоцитопения. В мазке крови обнаруживается базофильная зернистость эритроцитов, тельца Паппенгеймера. Эритроциты часто уменьшены в размерах (микроцитарная анемия), имеют аномальную форму.
- Биохимические исследования. Сывороточное железо, уровни ферритина и трансферрина повышены, ОЖСС – снижена. Отмечается непрямая гипербилирубинемия, повышение ЛДГ. Может выявляться дефицит витамина В6. При токсической СБА показано исследование содержания свинца в крови.
- Генодиагностика. Осуществляется при подозрении на наследственную форму сидеробластной анемии. Диагноз считается достоверным при выявлении мутаций в причинных генах.
- Исследование мочи. Исследование порфиринов в суточной моче показывает их повышенную экскрецию. Результаты десфералового теста демонстрируют выведение с мочой значительного количество железа.
- Миелограмма. Цитологическая картина пунктата костного мозга указывает на гиперплазию эритроидного ростка миелопоэза. Более 40% предшественников эритроцитов представлены кольцевидными сидеробластами.
- Биопсия внутренних органов. При биопсии печени в гепатоцитах обнаруживаются депозиты железа, иногда – признаки цирроза. Возможно проведение биопсии селезенки, поджелудочной железы.
Лечение сидеробластной анемии
При токсических и лекарственных формах СБА в первую очередь устраняют провоцирующий фактор (отменяют ЛС, проводят дезинтоксикационную терапию и т.д.). Лекарственная терапия сидеробластной анемии включает назначение следующих препаратов:
- Витамин В6. Пиридоксинзависимые формы (некоторые наследственные, алиментарные, алкогольные) поддаются терапии пиридоксина гидрохлоридом или пиридоксальфосфатом. При положительном отклике проводят длительные курсы большими дозами вит. В6 с последующей поддерживающей витаминотерапией.
- Гормонотерапия. Показана пациентам с пиридоксин-резистентной формой сидеробластной анемии. Назначаются анаболические гормоны, андрогены, эритропоэтин.
- Хелаторная терапия. Введение дефероксамина направлено на удаление избытка железа из организма, уменьшение степени выраженности гемосидероза. Для коррекции перегрузки железом также может быть использована флеботомия.
- Вспомогательная терапия. Включает назначение фолиевой кислоты, антиоксидантов (вит. Е, липоевой кислоты), гепатопротекторов.
Прогноз и профилактика
Прогноз при сидеробластной анемии обусловлен ее этиологией. Лучше поддаются коррекции пиридоксин-зависимые и некоторые приобретенные формы (лекарственные, алиментарные). Существенно снижена продолжительность жизни у лиц с СБА, трансфузионно-зависимыми, рефрактерными к лечению, ассоциированными с лейкемией, синдромом Пирсона. Профилактика, прежде всего, касается вторичных сидеробластных анемий: следует полноценно питаться, принимать витаминные комплексы, не допускать интоксикаций (этанолом, свинцом) и контакта с вредными веществами. Для исключения наследственных СБА рекомендуется генетическое консультирование.
3. Клинический случай X-сцепленной сидеробластной анемии с новой миссенс-мутацией cd518 ttg-ttt (leu518phe) в гене alas2. и соавт.// Гематология и трансфузиология. – 2020.
4. Морфология анемий и гемобластозов/ Макаров И.Ю., Меньщикова Н.В., Дубяга Е.В., Левченко Н.Р. – 2018.
Дизэритропоэтическая анемия
Дизэритропоэтическая анемия — общее название группы патологий, в основе которых лежат нарушения костномозгового кроветворения (гемопоэза). Она встречается при поражении красного костного мозга, экзогенных воздействиях, дефиците нутриентов (цианокобаламина, фолиевой кислоты, железы). Основные симптомы: бледность кожи, частые головокружения, повышенная утомляемость и одышка при физической нагрузке. Диагностика анемии включает клинические и биохимические исследования крови, изучение костномозговых пунктатов, обследование органов ЖКТ. Лечение подбирается дифференцировано в соответствии с этиологическими факторами заболевания.
Анемиями разной степени выраженности страдает 24,8% населения планеты. Среди беременных женщин они встречаются у 41,8%, среди небеременных —у 30,2%. У мужчин состояние развивается намного реже — в 12,7% случаев. Распространенность проблемы среди пожилого населения достигает 23,9%. Дизэритропоэтические нарушения составляют до 88% от всех видов анемий, имеют тяжелые осложнения и не всегда поддаются лечению, что подчеркивает актуальность патологии в практике гематолога.
Поскольку дизэритропоэтические анемии составляют большинство нарушений красного ростка гемопоэза, их этиологическая структура отличается большим разнообразием. Особую группу занимают наследственные заболевания, вызванные генными мутациями: гемоглобинопатии, талассемии, анемия Фанкони. Остальные причины подразделяются на следующие категории:
- Экзогенные влияния. Образования эритроцитов в костном мозге ухудшается под действием физических (радиация), химических (яды, лекарства — цитостатики, некоторые антибиотики), биологических факторов (вирусы гепатитов, Эпштейн-Барр).
- Дефицит нутриентов. Чаще болезнь возникает вследствие недостатка железа из-за алиментарных нарушений, чрезмерного расходования этого микроэлемента (при хронических кровотечениях, беременности, воспалительных реакциях). Реже симптомы вызваны нехваткой витамина В12, фолиевой кислоты.
- Онкопатология. Опухоли системы крови (лейкозы) и метастазы в костный мозг замещают нормальные ростки гемопоэза, снижают образование эритроцитов. Также при онкологических процессах ухудшается усвоение полезных веществ в кишечнике, чем обусловлена нутритивной недостаточностью.
Механизм развития болезни определяется этиологическими факторами. Экзогенные вредные воздействия нарушают синтез белков и нуклеиновых кислот в стволовых клетках, провоцируя их гипоплазию, а также изменяют параметры физико-химической среды костного мозга. В некоторых случаях патогенез дизэритропоэтических расстройств дополняется прямым разрушением клеток-предшественниц цитотоксическими лимфоцитами, специфическими антителами.
При дефицитных состояниях отмечаются нарушения на разных этапах образования эритроцита, насыщения его структурно полноценным гемоглобином. При низком содержании В12 либо фолиевой кислоты патология формируется на стадии синтеза ДНК и деления красных кровяных телец. Нехватка железа снижает образование гема, нарушает его соединение с глобином. Железодефицит также уменьшает число ферментов в эритроцитах, снижает устойчивость клеток к гемолизу.
- Апластические процессы. Развиваются при повреждении стволовых костномозговых клеток. В отдельную разновидность выделяют метапластические состояния, при которых красный росток кроветворения вытесняется опухолевыми клетками.
- Дефицитные состояния. Связаны с дефицитом химических веществ, необходимых для формирования эритроцитов. К ним относят мегалобластные (В12-дефицитные, фолиеводефицитные), железодефицитные, порфиринодефицитные (железорефрактерные).
- Талассемии. Формируются при генетически обусловленных нарушениях структуры белковых соединений гемоглобина. На основе данных о локализации генной мутации бывают альфа-, бета- и дельта-талассемии.
- Гемоглобинопатии. Проявляются при наследственном изменении структуры молекулы гемоглобина, синтезе дефектных белков. Самый известный представитель этой группы — серповидно-клеточная анемия.
Симптомы дизэритропоэтических анемий
Клиническая картина состоит из общих признаков недостатка гемоглобина и патогномоничных проявлений, вызванных первопричиной болезни. К основным симптомам относят слабость, быструю утомляемость, снижение работоспособности — признаки хронической гипоксии. Также пациенты жалуются на одышку, непереносимость физических нагрузок.
Типичные признаки анемической гипоксии включают частые приступы головокружения, шум в ушах, общее недомогание. Зачастую у больных снижается аппетит, наблюдаются расстройства полового влечения. Важным симптомом считается патологическая бледность кожных покровов, видимых слизистых, ногтевых лож. Длительно протекающая анемия приводит к разрушению ногтевых пластин по типу койлонихии.
Патогномоничные симптомы дефицитных дизэритропоэтических анемий: при нехватке В12 — «малиновый язык», нарушение чувствительности конечностей, при нехватке железа — трещины в углах рта, выпадение волос, извращение вкусовых пристрастий. Анемические состояния у страдающих онкопатологией сопровождаются потерей веса, увеличением лимфатических узлов, частыми инфекционными заболеваниями.
При апластическом варианте нарушаются все ростки кроветворения, поэтому в крови снижается уровень лейкоцитов, тромбоцитов. Классические признаки болезни дополняются частыми инфекциями на фоне снижения иммунитета, спонтанными кровотечениями, беспричинным появлением кровоподтеков на коже. При всех видах дизэритропоэтических анемий бывают кардиопатологии, которые проявляются миокардиодистрофией, сердечной недостаточностью.
Тяжелое течение чревато развитием анемической прекомы, для которой типична сильная сонливость, тахикардия, расстройства сознания. Если человеку вовремя не оказать помощь, состояние переходит в кому: пациент теряет сознание, у него снижаются рефлексы, нарушается дыхание и кровообращение. Особо опасна пернициозная кома, характеризующаяся резкой гипотермией, арефлексией, критической ишемией головного мозга.
При физикальном осмотре гематолог находит внешние симптомы анемии, изучает состояние придатков кожи, оценивает основные показатели работы сердца. Патогномоничные признаки, такие как «малиновый язык», сидеропенический синдром и т. д., наталкивают врача на причины нарушений гемопоэза. Для подтверждения диагноза и выяснения этиологических факторов назначают полный комплекс обследований, в который входят:
- Гемограмма. В результатах анализа крови специалист обращает внимание на падения числа эритроцитов ниже возрастной нормы, уменьшение показателя гемоглобина. Врач уточняет вид дизэритропоэтических анемий по цветовому показателю, наличию патологических форм клеток (мегалобластов, микроцитов, пойкилоцитов), уровню ретикулоцитов.
- Биохимические тесты. Железодефицитные состояния диагностируют по снижению уровней ферритина и трансферрина, повышению железосвязывающей способности сыворотки (ОЖСС). Для верификации других дизэритропоэтических анемий используют анализ крови на В12, фолиевую кислоту. Чтобы исключить гемолитический характер патологии, определяют уровень общего и непрямого билирубина.
- Пункция костного мозга. Исследование костномозговой ткани показывает угнетение ростков кроветворения (при апластической анемии), замещение их мутантными злокачественными клетками (при лейкозе), снижение числа сидеробластов (при недостатке в организме железа).
- Обследование ЖКТ. ЭФГДС и колоноскопия показаны больным с соответствующими жалобами для исключения хронических кровопотерь, выявления симптомов атрофического гастрита. Для уточнения диагноза эндоскопию дополняют рентгенографией с контрастированием, УЗИ органов брюшной полости, анализом кала на скрытую кровь.
Лечение дизэритропоэтических анемий
Консервативная терапия
Лечение проводится в 2-х направлениях: улучшение гематологических показателей и устранение первопричины заболевания. При нутриентных дефицитах необходима коррекция питания с насыщением рациона недостающими витаминами и микроэлементами. Диетотерапия дополняется пероральным или парентеральным введением железа, В12 или фолиевой кислоты, чтобы быстро восстановить гемопоэз.
Особую сложность представляет лечение апластических форм анемии. Учитывая причины болезни, пациентам назначают иммуносупрессивные препараты, анаболические стероиды, моноклональные антитела. При тяжелом течении любого вида дизэритропоэтической анемии в качестве экстренной помощи используют гемотрансфузионную терапию: переливание эритроцитарной массы, тромбоцитарной массы, гранулоцитарного концентрата.
Хирургическое лечение
Трансплантация гемопоэтических стволовых клеток — наиболее перспективное направление коррекции апластических, наследственных дизэритропоэтических анемий. Процедура повышает шансы на долгосрочную выживаемость, улучшает качество жизни больных. При врожденных нарушения кроветворения, сопровождающихся увеличением селезенки, показана спленэктомия.
Большинство дефицитных анемий успешно корректируются, тогда как при апластических дизэритропоэтических и генетически обусловленных заболеваниях прогноз сомнительный. Продолжительность жизни больного зависит от тяжести патологии, полноты применяемых терапевтических методов. Профилактика предполагает рациональное витаминизированное питание, назначение биодобавок людям из групп риска, предупреждение экзогенных воздействий на костный мозг.
1. Дизэритропоэтические анемии. Классификация. Этиология и патогенез железодефицитной анемии/ Н.П. Чеснокова, Т.А. Неважай, М.Н. Бизенкова, В.В. Моррисон// Международный журнал прикладных и фундаментальных исследований. — 2015.
2. Дизэритропоэтические анемии. Этиология и патогенез в12-дефицитной анемии, гематологическая характеристика/ Н.П. Чеснокова, Т.А. Неважай, М.Н. Бизенкова, В.В. Моррисон// Международный журнал прикладных и фундаментальных исследований. — 2015.
3. Анемии: виды, клинические проявления, лечение/ Е.Ф. Шевченко, П.Ю. Доронина// Научно-практический электронный журнал «Аллея Науки». — 2020.
Читайте также:
- Кровоснабжение тонкой кишки. Верхняя брыжеечная артерия. Топография верхней брыжеечной артерии. Аркады кишки.
- Метастазы в позвоночнике. Боль в шее при метастазах позвоночника.
- Липома и хондрома полости рта. Остеома полости рта
- Врожденная катаракта и киста глаза у эмбриона. Анофтальмия - циклоп
- Лечение и профилактика врожденного сифилиса у новорожденного
